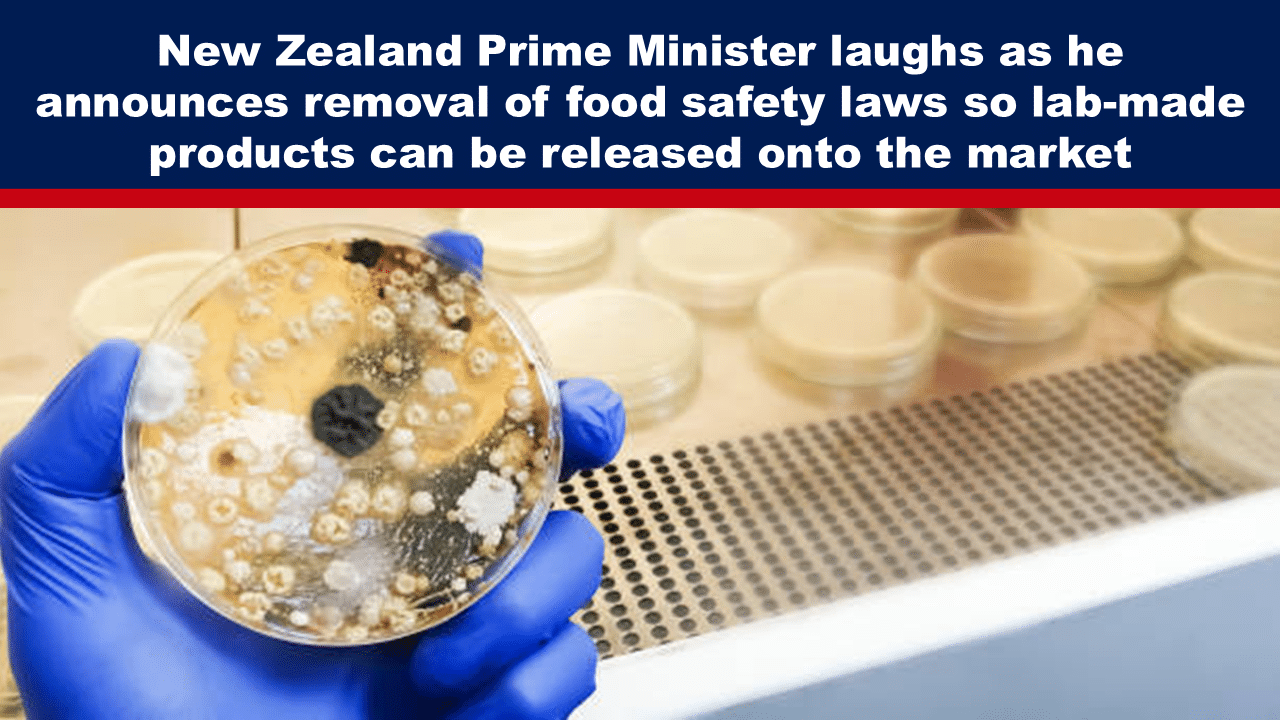

Last week in New Zealand, Judith Collins, Minister for Science and Technology, and Chris Luxon, Prime Minister, decided to introduce a policy change with a Laurel and Hardy double act on Twitter; it was full of bonhomie and laughter designed to mask a sinister intent.
Laural and Hardy were announcing new biotechnology gene editing laws.
Deregulation of biotechnology will contain provisions that take away our basic human rights of choice. They will change the face of our small island nation forever – yes, forever, Dr, Guy Hatchard says.
Let’s not lose touch…Your Government and Big Tech are actively trying to censor the information reported by The Exposé to serve their own needs. Subscribe to our emails now to make sure you receive the latest uncensored news in your inbox…
A Week in Politics That Stole Our Rights and Changed Our Nation Forever
By Dr. Guy Hatchard, 15 August 2024
According to their vaudeville performance, biotechnology deregulation will enable amazing scientists to mitigate climate change, improve our health, boost our horticulture, and grow our economy. Collins effused “it is so great to be part of this government.”Luxon agreed, calling it “an amazing day.” As he sees it, some laws formulated in 1996 to protect consumers make no sense in 2024 because they prevent incredibly smart biotechnology scientists from releasing their products into the environment without having to go through public scrutiny.
Luxon added, “We’re going to make sure we do it safely, don’t worry about that” (at this point Luxon appeared to be channelling Jacinda Ardern). It would be easy to poke fun, but the consequences are too far-reaching and serious for levity. The 1996 laws do not prevent biotech food products from reaching the market as Luxon implied. Instead, they require that gene-altered ingredients be labelled as such. In other words, Luxon is taking away our right of consumer choice, our right to know what we are eating. In the near future “incredibly smart scientists” will be deciding for us.
Aside from our right to know, there is one other very important reason for the 1996 law. It involves one word “traceability.” If novel gene-altered food substitutes are not labelled, there will be no way for anyone to find out if they are causing illness. Compulsory food labelling has been a fundamental part of our global food safety system since it was first introduced in 1913. Bypassing this principle is a key strategy of biotech marketing for the simple reason that consumers don’t want biotech foods and manufacturers don’t want to face lawsuits. Thus, in one stroke Luxon’s government has taken us back into the 19th century world of food adulteration, in his words: “amazing.”
Watching the video of Luxon and Collins I was forcibly struck by how far out of touch they are with reality. They appeared to me as a pair of simpletons smirking and chuckling with glee as they thought they could pass off iron pyrites as gold. We are still in the shadow of a pandemic era where incredibly “intelligent scientists” (???)were given free rein and funding to develop a deadly virus and then a botched vaccine that killed rather than cured.
Luxon and Collins were part of a parliament that forced it on us as a nation with promises of safety and efficacy. Currently, we have a rate of excess deaths more than 10% above the long-term trend. Yet here they are again with the same meaningless mantra: “Don’t worry, we will do it safely.”Anyone who swallows that needs to have their head examined. But this time the ante has been upped, if Luxon’s government has its way, we will be swallowing it without knowing we are.
The current national-led government aspires to a Thatcherite ideology whose narrative no longer fits the facts on the ground, not even close.
Our birth rate, along with those of other Western nations, has fallen so low that our population is no longer renewing itself, not even close. Before long, there won’t be enough youthful workers to keep the economy going, yet David Seymour is obsessed with the idea that poor people need to stop having children.
Our health service is in crisis because too many people are falling sick with heart disease, cancer and other illnesses in numbers that dwarf previous trends but the government believes this is due to administrative inefficiency.
The number of people suffering long-term disability is ballooning, but the government believes this is due to malingering.
These are all recognisable Thatcherite tropes, and they no longer fit the reality of social statistics. We are in the midst of a health crisis engineered by biotechnology. Our government wants to go further down that road by removing the very few safeguards that we have left. As we know very well by now, biotechnology edits can spread without limit and they can never be recalled. Luxon wants to deny us our right to know and he is laughing about it to our face on Twitter. We need to raise our voices and push back.
About the Author
Guy Hatchard, PhD, is a New Zealander who was formerly a senior manager at Genetic ID a global food testing and safety company (now known as FoodChain ID).
You can subscribe to Dr. Hatchard’s websites HatchardReport.com and GLOBE.GLOBAL for regular updates by email. GLOBE.GLOBAL is a website dedicated to providing information about the dangers of biotechnology. You can also follow Dr. Hatchard on Twitter HERE and Facebook HERE.
The Expose Urgently Needs Your Help…
Can you please help to keep the lights on with The Expose’s honest, reliable, powerful and truthful journalism?
Your Government & Big Tech organisations
try to silence & shut down The Expose.
So we need your help to ensure
we can continue to bring you the
facts the mainstream refuses to.
The government does not fund us
to publish lies and propaganda on their
behalf like the Mainstream Media.
Instead, we rely solely on your support. So
please support us in our efforts to bring
you honest, reliable, investigative journalism
today. It’s secure, quick and easy.
Please choose your preferred method below to show your support.
Categories: Breaking News, World News
Start prepping now, I’m starting to hoard essentials like tinned food. It makes sense.
What Jerks
WACKOS!!!! Total WACKOS Actually!!!
Part or all evil starting to show, only read the opening and can see this guy called a leader is either evil or just plain incompetent or has a low IQ of 0, but as many corrupted leaders are still pulling the wool over everybody’s heads for now till all wake up as I’m starting to see all evil of earth that we have verses the god of the real spirit, not good
WACKOS, ALL Of THEM Are WACKOS…….Is This Life Ever a (nice) Place?? Will It Ever Be a (nice) Place?? Was It Ever a (nice) Place, Really??? and what about OUR friends?? (yeah friends, uh huh…..) and OUR lovers?? too?? vice versa (lovers?? you mean: MESSING Around BUDDIES, Even when ONE gets CONTRACTED, meaning: marriage or getting hitched, vice versa, because: That’s ALL (love) really IS, in This Life: a CONTRACT, just like OUR friendships are TOO.) (like a combination of that movie or film scene from the Fly Two where they in the Lab show Him all of his daily life activities, are being monitored, and all of his daily relations, are PICKED OUT FOR him, (just like ALL of OUR lives Are Picked Out For us Here, before WE even Arrive or Get Here) meets the Depeche Mode song Everything Counts??? and vice versa…..pretty much It’s ALL Just a FREAKING CONTRACT!! None of It’s (real)…………
All WEF controlled.
easy answer STOP buying store meat and buy from local farmers
Consequences … I would advise people to watch alien hunter the movie to see what an uncontrolled consequence might be and not even intentional.
https://www.imdb.com/title/tt0327409/
In today’s world plausible because government oversight is corrupted by corporate profit.
This is super crass and dangerous and the CAUSE OF OBESITY IN THE UNITED STATES, my relatives won’t go near it and only eat ORGANIC! Don’t touch ANYTHING MAN MADE. BILL GATES THE EUGENIC MADMAN IS RESPONSIBLE. He is the largest owner of farmland in America! It would be a good idea to plant your own food in your own backyard WITHOUT PESTICIDES then you have ORGANIC! Can’t make it more clear THE DANGERS!
Hi
Cynthia,
When Bill Gates was in court a few years ago, he acted like a gibbering idiot.
I thought that was strange for a wealthy Microsoft investor.
That was when he was given new instructions about how to act, to escape jail.
Back in the 1970’s most Americans were thin. A fat person was rare. Go look at old time capsule videos on utube or watch movies from that era with crowd scenes. Now everyone is a land whale.
I think these people are demons in human form. The laughing at other people’s expense is so disturbing. It reminds me of Fauci smirking while telling us we needed to wear 4 face masks. They’re laughing at us. Do you think these two leptons will be eating lab meat and GMO salad?
Sounds as if all politicians at the top of that dirty pile have been bought and paid for by corporations the world over,